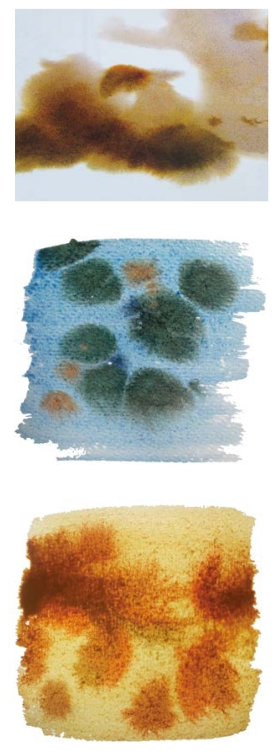

材料与工具的魅力 : 图说水彩画技法102例
-
1.1目录
-
1.2前 言 PREFACE
-
1.3Part 1 色彩,原来可以这样玩
-
1.3.1认识身边的水彩颜料
-
1.3.2常用技法
-
1.3.2.11.干底平涂
-
1.3.2.22.干底衔接
-
1.3.2.33.干底重叠
-
1.3.2.44.干底并置
-
1.3.2.55.湿底衔接
-
1.3.2.66.湿底重叠
-
1.3.2.77.渲 染
-
1.3.2.88.湿 渗
-
1.3.2.99.浅色破深色
-
1.3.2.1010.深色破浅色
-
1.3.2.1111.先湿后干
-
1.3.2.1212.先干后湿
-
1.3.2.1313.干湿分明
-
1.3.2.1414.纸上混色
-
1.3.2.1515.笔上混色
-
1.3.2.1616.调色盘上的灰色
-
1.3.2.1717.沉 淀
-
1.3.2.1818.分块着色
-
1.3.2.1919.留 白
-
1.3.2.2020.白 色
-
1.3.2.2121.黑 色
-
1.3.3拓展技法
-
1.3.3.122.白铅添画
-
1.3.3.223.铅笔淡彩
-
1.3.3.324.钢笔淡彩
-
1.3.3.425.圆珠笔淡彩
-
1.3.3.526.亚克力水彩
-
1.3.3.627.油画棒淡彩
-
1.3.3.728.蜡笔淡彩
-
1.3.3.829.彩铅淡彩
-
1.3.3.930.转 印
-
1.3.3.1031.水 印
-
1.3.3.1132.湿 压
-
1.4Part 2 感受纸张的表现力
-
1.4.1水彩纸的特性
-
1.4.2常用技法
-
1.4.2.133.裱 纸
-
1.4.2.234.水彩纸
-
1.4.2.335.色 纸
-
1.4.2.436.宣 纸
-
1.4.2.537.卡 纸
-
1.4.2.638.水彩画布
-
1.4.2.739.做 底
-
1.4.3拓展技法
-
1.4.3.140.皱 纸
-
1.4.3.241.粘 贴
-
1.5Part 3 你不可忽视的用笔方法
-
1.5.1熟悉手中的画笔
-
1.5.2常用技法
-
1.5.2.142.刷 铺
-
1.5.2.243.勾 勒
-
1.5.2.344.侧 锋
-
1.5.2.445.逆 锋
-
1.5.2.546.乱 锋
-
1.5.2.647.拖 笔
-
1.5.2.748.揉 戳
-
1.5.2.849.皴 擦
-
1.5.2.950.轻 扫
-
1.5.2.1051.飞 白
-
1.5.2.1152.吸除堆积水色
-
1.5.2.1253.点状笔触
-
1.5.2.1354.线状笔触
-
1.5.2.1455.块状笔触
-
1.5.2.1556.圆润笔触
-
1.5.3拓展技法
-
1.5.3.157.滴 色
-
1.5.3.258.弹 色
-
1.6Part 4 驾驭水的魔性
-
1.6.1水的魔力
-
1.6.2常用技法
-
1.6.2.159.浸 纸
-
1.6.2.260.晕 化
-
1.6.2.361.滴 水
-
1.6.2.462.弹 水
-
1.6.2.563.喷 水
-
1.6.2.664.洗 涤
-
1.6.2.765.流 动
-
1.6.2.866.水 冲
-
1.6.2.967.扩 散
-
1.6.2.1068.透 明
-
1.6.3拓展技法
-
1.6.3.169.水 渍
-
1.6.3.270.色块硬边处理
-
1.7Part 5 辅助材料,让画面更“美味”
-
1.7.1锦上添花的辅助材料
-
1.7.2常用技法
-
1.7.2.171.撒 盐
-
1.7.2.272.留白液遮蔽
-
1.7.2.373.涂 蜡
-
1.7.2.474.涂 油
-
1.7.3拓展技法
-
1.7.3.175.撒洗衣粉
-
1.7.3.276.酒精分色
-
1.7.3.377.浆 彩
-
1.7.3.478.皂 液
-
1.8Part 6 体验辅助工具的趣味
-
1.8.1辅助工具的神来之“笔”
-
1.8.2常用技法
-
1.8.2.179.橡皮擦拭
-
1.8.2.280.干 刮
-
1.8.2.381.湿 刮
-
1.8.2.482.湿画深色线条
-
1.8.2.583.砂纸打磨
-
1.8.2.684.喷 色
-
1.8.2.785.纸巾吸沾
-
1.8.2.886.牙刷弹色
-
1.8.2.987.皱纸沾印
-
1.8.2.1088.布团沾印
-
1.8.2.1189.线绳与毛发沾印
-
1.8.2.1290.海绵沾印
-
1.8.2.1391.丝瓜瓤沾印
-
1.8.2.1492.保鲜膜沾压
-
1.8.2.1593.胶带纸遮挡
-
1.8.3拓展技法
-
1.8.3.194.吹 色
-
1.8.3.295.叶片沾印
-
1.8.3.396.窗纱沾印
-
1.8.3.497.小米沾印
-
1.8.3.598.纸板刮画
-
1.8.3.699.气泡垫沾印
-
1.8.3.7100.镂版漏印
-
1.8.3.8101.手指压印
-
1.8.3.9102.药棉吸沾
-
1.8.4插图作者